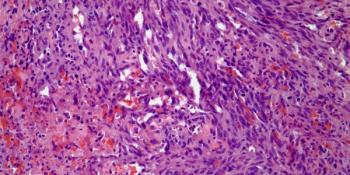

A 21-year-old woman develops a nodule in her left breast, and a biopsy is obtained. What your diagnosis?

Your AI-Trained Oncology Knowledge Connection!


A 21-year-old woman develops a nodule in her left breast, and a biopsy is obtained. What your diagnosis?

A 48-year-old man presents with a skin mass on his left shoulder, and a biopsy is performed. What is your diagnosis?

A 43-year-old woman develops a mass in her left breast, and a biopsy is obtained. What is your diagnosis?

A 37-year-old woman presents with a small nodule in her right breast, and a biopsy is obtained. What is your diagnosis?

A 28-year-old woman presents with a vulvar mass, and a biopsy is obtained. What is your diagnosis?

A 66-year-old woman presented with conjunctival redness and irritation of the right eye. An eye exam revealed a painless, pink, fleshy patch with a smooth surface in the superior aspect of nasal bulbar conjunctiva of the right eye. A biopsy of the lesion was performed. What is the diagnosis?

A 45-year-old woman presents with a lesion near the pancreas. What is your diagnosis?

A 67-year-old man presents with a mass in his right thigh, and a biopsy is performed. What is your diagnosis?

A 60-year-old woman presents with an ovarian tumor, and a biopsy is obtained. What is your diagnosis?

A 17-year-old boy presents with a lesion in the face. What is your diagnosis?

A 27-year-old man presents with a lesion in the right side of his neck. What is your diagnosis?
A 48-year-old woman presents with a mass in her right breast, and a biopsy is obtained. What is your diagnosis?

A 38-year-old man presents with a fever and headaches. A brain mass is detected, and a biopsy is obtained. What is your diagnosis?

A 44-year-old man presents with a lesion on his right upper back, and a biopsy is performed. What is your diagnosis?

A 34-year-old woman presents with a lesion in the salivary gland, and a biopsy is obtained. What is your diagnosis?

A 57-year-old man presents with hematuria, and a bladder biopsy is obtained. What is your diagnosis?

A 52-year-old man presents with a lesion of the lower back, and a biopsy is performed. What is your diagnosis?

A 38-year-old woman presents with a lesion in the pancreas, and a biopsy is obtained. What is your diagnosis?

A 68-year-old man presents with dysuria and hematuria, and a bladder biopsy is obtained. What is your diagnosis?